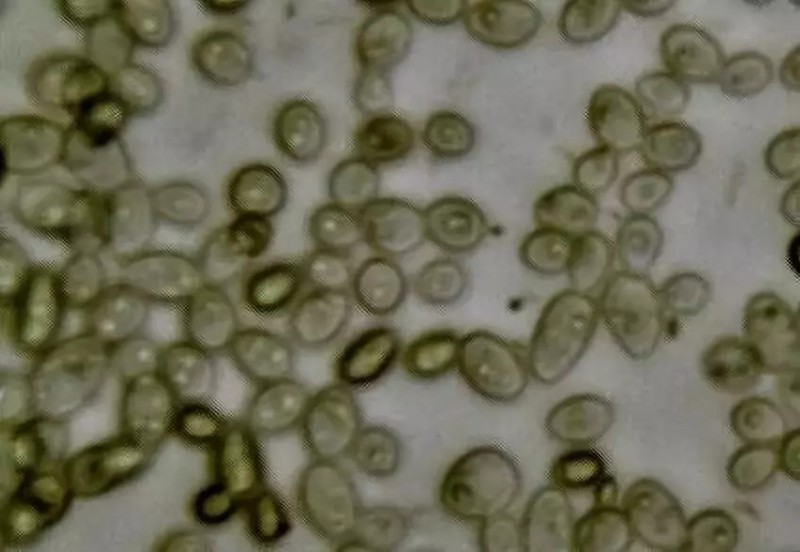

康普茶的前世今生~
如果你去欧美高端超市的饮料专柜里,你会发现一类名叫Kombucha(康普茶)的神奇饮料。
这种新兴的饮料在几年前还无人问津,但在最近几年突然火了起来,成为了欧美的网红饮料,并迅速成长为了一个成熟的品类,霸占了欧美的饮料市场。


▲康普茶的Google趋势图
如果你认为它是一种全新的饮料,那你就错了——其实这东西,我国在大约上世纪 80 年代的时候就流行过。
最流行的时候,它可谓是红遍大江南北,如果没喝过它,都不好意思出门。但它很快就销声匿迹了。现在的90后,00后怕是听都没听说过了。
下面我们就来给大家讲讲,过气饮料康普茶的故事……
1
过气的网红饮料
康普茶起源于中国。具体起源年代已不可考,但一般认为是在环渤海地区以及东北地区,那里的人们至少 200 年前就开始喝这种饮料了。
我们的年轻读者,如果你没听过这种饮料,没关系,回去问问你的爸爸妈妈,有没有听说过以下名字:
红茶菌
海宝
胃宝
对,这都是制作「康普茶」的原料的别名。可能有些读者看到这里,就已经被勾起了酸酸甜甜的回忆吧。
80年代最流行的那阵子,家家户户都在养红茶菌。养红茶菌就像养蘑菇一样。开始时只是薄薄的一小片,但只要做一瓶红茶,放一点糖,再把红茶菌放在里面,用纱布封上口。不出几天时间,你就能获得一杯酸酸甜甜的清凉饮料——康普茶啦。
更神奇的是,红茶菌在这个过程中会越长越大。它是可以重复使用的。你做得越多,红茶菌就会变得越大越厚。如果你喜欢,你还可以把多余的红茶菌分给小伙伴们!

听着是不是特别神奇?那么,红茶菌的真身到底是什么呢?
2
红茶菌的技术
红茶菌本质上是一个微生物共生群落(Symbiotic culture of bacteria and yeast,SCOBY)。
用人话来解释就是一大堆不同种类的微生物聚集在一起,形成的群落。在这个群落里的各个微生物具有互利共生的关系,某一种微生物的代谢物恰好是另一种的养料。
▲红茶菌中菌种的显微照片
红茶菌的主要菌种包括多种酵母和一些细菌。酵母成分通常包括下面几种:
酿酒酵母(Saccharomyces cerevisiae)
布鲁塞尔酒香酵母(Brettanomyces bruxellensis)
星形假丝酵母(Candida stellata)
粟酒裂殖酵母(Schizosaccharomyces pombe)
拜耳接合酵母(Zygosaccharomyces bailii)
它们负责发酵红茶中加入的那些糖,生产酒精,顺便提供一些特别的风味。
说完了酵母部分,再来看看细菌部分。红茶菌的细菌成分,通常一定会包含以下这种:
木质葡糖醋杆菌(Gluconacetobacter xylinus)
它负责分解酒精产生醋酸。这样一来,康普茶中的酒精浓度就不至于太高,而它的味道也变得酸甜可口。
这种细菌还有一个能力就是生产纤维素,是它把整个共生群落用纤维素紧紧包裹在一起,成为了胶冻状的固体。大家熟悉的椰果,也是用同类的细菌生产出来的。
▲木质葡糖醋杆菌生产的细菌纤维素
所以,康普茶本质上是一种发酵茶饮料。经过了细菌和酵母的共生发酵之后,红茶中的糖被转换成了酒精和醋酸。整个茶的味道变得酸甜而富有层次感。而细菌和酵母的繁殖和纤维素的生产,使得红茶菌变得越来越大。
这样一种有意思的饮料,为什么会在中国销声匿迹,成为过气饮料呢?
3
自制康普茶的安全风险
其实归根结底,还是食品安全。80年代流行的康普茶,都是大家用「红茶菌」在自己家自制出来的。而我们在之前的文章中多次提过,一切涉及到发酵的东西,自制的危险系数都是很高的。

特别是家里卫生条件不够,只要稍有不慎,就容易发生杂菌污染的情况。甚至霉菌侵入,都是比较常见的。
特别是像红茶菌这种东西,很多情况下还可以「共享」。我家发酵多出来的分给你家用。在这种情况下,如果红茶菌被杂菌污染,往往还会像疫病一样,通过这样的方式「扩散」开来。

所以,在这种情况下,随着红茶菌的流行,越来越多的人由于杂菌污染,被喝进了医院。这时,有些媒体就用诸如“红茶菌不能喝”,“红茶菌致癌”之类的言论制造恐慌。慢慢地,红茶菌也就没有人喝了。
4
再红一波?
目前在欧美流行的康普茶都是完全工业化的产品。它们是在特制的发酵罐里发酵制得的。在这个过程中,温度,菌群,发酵时间都是精确控制的,食品安全风险也被降到了最低。
欧美的康普茶往往是以健康作为卖点的。商家往往会宣称这样的产品可以减肥、排毒、提高免疫力。但是,从科学上说,康普茶的这些保健作用都没法站住脚跟。
我们日常生活中,还是应该把它当做一种好喝的饮料来喝,而不要执着于那些没有得到证明的保健效果。
最近几年,随着欧美的流行,也有很多食品公司准备把这个发酵茶品类重新带回国内。目前在国内的一些高端超市里,已经可以见到康普茶的身影了。
在未来,也许这个昔日的过气饮料又会重新焕发生机,成为新一轮的网红。让我们拭目以待吧。


评论